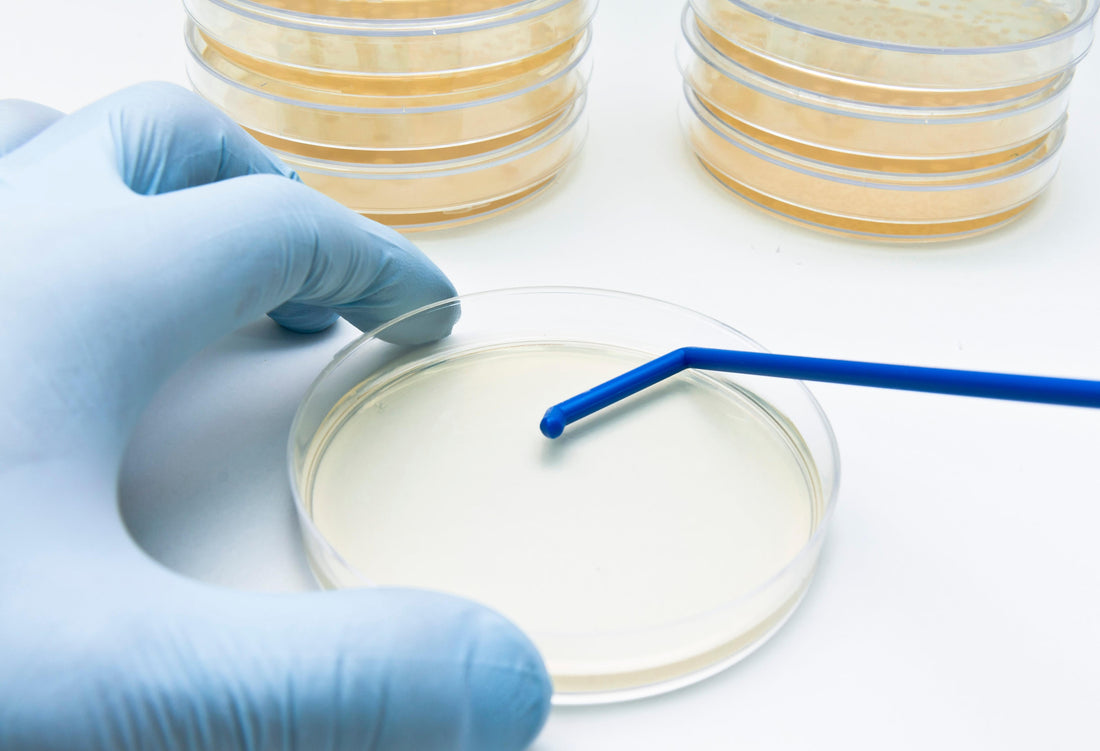

Agar vs. Gellan Gum: Which to Choose?
As a content and community manager, I leverage my expertise in plant biotechnology, passion for tissue culture, and writing skills to create compelling articles, simplifying intricate scientific concepts, and address your inquiries. As a dedicated science communicator, I strive to spark curiosity and foster a love for science in my audience.


Plants, like all other living organisms on earth, require minerals and nutrients for their growth and development. In nature, soil acts as a nutrient reservoir and the support system for their establishment at a place. However, what happens when they are brought to labs?
Growing plants in a lab environment is a tough job, as specific nutrient requirements of the plant need must be fulfilled for its survival. And that’s not it! They also require a particular environment, with specific temperatures and humidity at different growing stages. However, the solution to all these problems is available today.
Specific machines have been developed to set the temperature and humidity of the room in which plants are grown. For nutrient supply, different types of media are available that fulfill the nutrient requirement of the plants. But, what provides the stability in the media? What holds it firmly for its establishment in the media? The answer to these questions is "solidifying agents".
Solidifying agents are added to the media to create a semi-solid/solid surface for the explants cultured in the media. The agents help the explants to establish themselves and grow. Different solidifying agents are present to date such as agar, alginate, phytagel, and transfer gel. Each of this is slightly different in characteristics (solidifying temperature, pH) and serve different purposes. These gelling agents have a strong influence on the growth and development of various explants.
In this article, we'll discuss the properties and applications of agar and gellan gum.
Agar
Agar is a mixture of agarose (a linear polysaccharide) and agaropectin (a heterogeneous mixture of smaller molecules). It is obtained from the cell walls of a species of red algae, Gelidium corneum and tengusa, and Gracilaria ogonori (division Rhodophyta), as an amorphous and translucent product. It is commercially available in the form of powder and mixed with media and water for the growth of microorganisms, plant cells, or tissues.
It is the most common gelling agent used in plant tissue culture. The solidification of the agar is pH-dependent and the optimal pH range occurs between 5.2 and 5.6. The pH of the media should be adjusted after adding agar. It dissolves readily in boiling water and solidifies at 37℃ into a firm gel. The normal concentration range of agar added in the media is 6-8 g/L (0.5%-10%). Agar is stable for a prolonged period and does not bind excessively with media components.
Gellan Gum
Gellan gum was isolated and discovered in 1978 from a bacteria Sphingomonas elodea. It is a water-soluble anionic polysaccharide, initially used as a substitute for agar in various clinical bacteriological media. Structurally, it is composed of a repeating unit of tetrasaccharide, which consists of two residues of D-glucose, one residue of L-rhamnose, and one residue of D-glucuronic acid.
Gellan gum products fall into two categories, depending on the number of acetate groups attached to the polymer. The products containing fewer acetate groups form firm, non-elastic, brittle gels, whereas the products containing a large number of acetate groups form soft and elastic gels.
Gellan gum products, when added to the media, produce a more transparent gel, which allows for better observation of root growth, identification of contamination at an early stage, and facilitates light for microscopic analysis of tissue or cells, which is difficult to achieve with agar. They are also very useful in culturing thermophilic microorganisms.
Gellan gums can withstand temperatures up to 120 ℃ and only half its strength is required to reach an equivalent gel strength as agar. In long-term cultures, gellan gums tend to liquefy because of disturbance in structural crosslinking on pH change and depletion of salts. It is added to the media in a concentration range of 2-4 g/L. When adding gellan gums to media, rapidly stir your mixture at room temperature to avoid clumping.
The 0.2% of gellan gum added to the media can substantially modify the MS medium concerning elements like Na (sodium), Al (aluminum), Sr (strontium), Ti (titanium), Cu (copper), and V (vanadium). Whereas agar only disturbs a bit of the sulfur and silica composition in the media. Further, agar has phenolic impurities, where no such impurity is present in gellan gum.
A chart showing differences in Agar and Gellan gum.
Properties | Agar | Gellan Gum |
Melting temperature | 85℃ | 110℃ |
Gelling temperature | 37℃ | Low acyl gellan gum products: 25 ℃
High acyl gellan gum products: 65 ℃ |
Concentration | 6-8 g/L (0.5%-10%) | 2-4 g/L (0.2-0.4%) |
Transparency | Low (cloudy) | Very high |
Modification of MS media | Modify by altering sulfur, calcium, and silicon in the media | Modify by altering Na, Al, Sr, Ti, Cu, and V in the media. |
Phenolic impurity | Present | Absent |
Price | Cheaper than gellan gum | Costlier than agar |
Application |
|
|
The choice of gelling agent also depends on your experiments, so other than the concentration, price, and transparency of gel, some other factors need to be determined. For example, some studies have shown that seeds of rice, when grown on agar and gellan gum, showed the same growth rate. So, consider all properties and your requirements before you choose any solidifying agents for your cultures!
References
- Scherer, P. A., Müller, E., Lippert, H., & Wolff, G. (1988). MULTIELEMENT ANALYSIS OF AGAR AND GELRITE IMPURITIES INVESTIGATED BY INDUCTIVELY COUPLED PLASMA EMISSION SPECTROMETRY AS WELL AS PHYSICAL PROPERTIES OF TISSUE CULTURE MEDIA PREPARED WITH AGAR OR THE GELLAN GUM GELRITE. Acta Horticulturae, (226), 655–658. DOI:10.17660/actahortic.1988.226.9
- https://phytotechlab.com/media/documents/ProductLi...
- https://www.britannica.com/topic/agar-seaweed-prod...
- https://en.wikipedia.org/wiki/Agar
- https://en.wikipedia.org/wiki/Gellan_gum.
Blog Categories
View by Level
Popular Blogs

Why Carbohydrate Sources Matter in Plant Tissue Culture Media
Introduction Ever wondered why a simple sugar can make or break your plant tissue culture success? It’s a question that...
Read More
How Tissue Culture Supports Vertical Farming and Urban Agriculture?
Introduction If you've ever seen a large-scale vertical farm, with its towering racks of perfect, vibrant greens, you might wonder...
Read MoreSubscribe to Our Newsletter
Join the conversation
Your email address will not be published. Required fields are marked